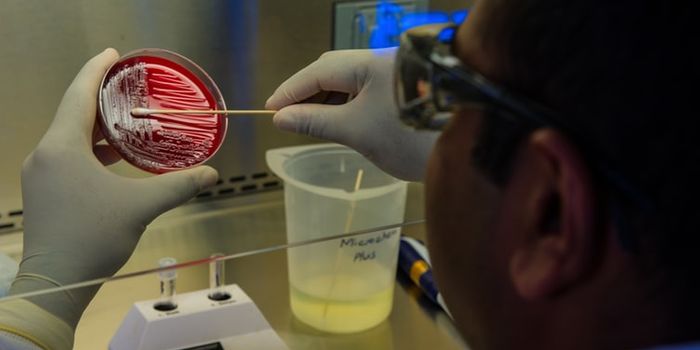
Antibiotics for Superbug Infections?

Pulmonary Fibrosis
Pulmonary Fibrosis: is a lung disease that happens when lung tissue becomes damaged. The thickened tissue makes it more difficult for your lungs to work properly. As pulmonary fibrosis worsens, you become more short of breath.
-
JAN 18, 2024CardiologySupplementing with omega-3 fatty acids may improve a range of health conditions.Written By: Savannah LoganMAY 01, 2023Cell & Molecular BiologyScientists have recently completed a lengthy study in which over 200 people with premature aging disorders that are caus ...Written By: Carmen LeitchJAN 12, 2023Drug Discovery & DevelopmentInsilico Medicine is a clinical-stage artificial-intelligence (AI)-based research and development company seeking to dis ...Written By: Greta AnneOCT 31, 2022CardiologyCystic Fibrosis (CF) impacts roughly 35,000 people in the United States. CF results in a mutated form of the cystic fibr ...Written By: Christopher DiMaioJUL 25, 2022CardiologyA new study from the University of Virginia School of Medicine and recently published in Science discusses how the loss ...Written By: Laurence Tognetti, MScJUN 03, 2021Drug Discovery & DevelopmentResearchers behind a large trial of antibiotics for chronic lung diseases have found that that the drugs are ineffective ...Written By: Annie LennonAPR 29, 2021MicrobiologyFor over a year now, scientists and clinicians have been trying to understand why the SARS-CoV-2 virus causes such deadl ...Written By: Carmen LeitchFEB 08, 2021TechnologyA blood count is essential to ascertain a patient’s health. One of the parameters measured is hemoglobin level&mda ...Written By: Nouran AminSEP 21, 2020ImmunologyOver 85 massive wildfires have swept through the West Coast, devastating communities in Washington, Oregon, and Californ ...Written By: Tara FernandesAUG 17, 2020ImmunologyA protein produced by the nervous system seems to play a role in regulating the immune system. For people with inflammat ...Written By: Kara MarkerJUL 23, 2020ImmunologyScientists at the Stanford Institute for Stem Cell Biology and Regenerative Medicine have discovered a striking parallel ...Written By: Tara FernandesAPR 19, 2020Cell & Molecular BiologyThe causes of chronic obstructive pulmonary disease are unclear and there is currently no treatment, but new work may he ...Written By: Carmen LeitchFEB 20, 2020Drug Discovery & DevelopmentAntibiotics for superbug infections? A study published in the Proceedings of the National Academy of Sciences claims tha ...Written By: Nouran AminAPR 12, 2019Health & MedicineSarcoidosis is an inflammatory disease that involves the formation of non-caseating granulomas, a cluster of macrop ...Written By: Dena ArutaMAR 04, 2019Health & MedicineSarcoidosis is a rare, granulomatous disease that is found in the lungs of 90% of people diagnosed, but it can affect an ...Written By: Dena ArutaJAN 07, 2019Drug Discovery & DevelopmentAccording to a study published in the journal EBioMedicine, the very first results on the treatment of a deadly age-rela ...Written By: Nouran AminAUG 05, 2018Genetics & GenomicsThis rare type of cell seems to play a major role in cystic fibrosis.Written By: Carmen LeitchJUL 09, 2018CardiologyUtilizing computational modeling to create a more successful tissue-engineered heart valve.Written By: Caitlin WilliamsJUN 11, 2018Clinical & Molecular DXDiagnosing mild-to-moderate asthma can be difficult to diagnose, especially when scientists need to rule out other respi ...Written By: Kara MarkerMAY 28, 2018CancerWilms tumors occur in young children and treatment for lung metastases has included radiotherapy. A Phase III Clinical ...Written By: Mauri BrueggemanMAY 15, 2018Drug Discovery & DevelopmentTreating the common cold has never been simple and finding effective options has baffled scientists for centuries. The c ...Written By: Nouran AminMAY 22, 2017Cell & Molecular BiologyNew lung organoids open up new research possibilities for the study of human disease.Written By: Carmen LeitchFEB 26, 2017CardiologyPulmonary fibrosis can inhibit breathing due to scarring in the lungs. However, fibrosis is not limited to the lungs; it ...Written By: Kara MarkerSEP 19, 2016Clinical & Molecular DXIn the past year, biomedical engineers have created lab-grown heart cells, retinal nerve cells, and even vocal cords tha ...
JAN 18, 2024
Cardiology
Supplementing with omega-3 fatty acids may improve a range of health conditions.
Written By:
Savannah Logan
MAY 01, 2023
Cell & Molecular Biology
Scientists have recently completed a lengthy study in which over 200 people with premature aging disorders that are caus
...
Written By:
Carmen Leitch
JAN 12, 2023
Drug Discovery & Development
Insilico Medicine is a clinical-stage artificial-intelligence (AI)-based research and development company seeking to dis
...
Written By:
Greta Anne
OCT 31, 2022
Cardiology
Cystic Fibrosis (CF) impacts roughly 35,000 people in the United States. CF results in a mutated form of the cystic fibr
...
Written By:
Christopher DiMaio
JUL 25, 2022
Cardiology
A new study from the University of Virginia School of Medicine and recently published in Science discusses how the loss
...
Written By:
Laurence Tognetti, MSc
JUN 03, 2021
Drug Discovery & Development
Researchers behind a large trial of antibiotics for chronic lung diseases have found that that the drugs are ineffective
...
Written By:
Annie Lennon
APR 29, 2021
Microbiology
For over a year now, scientists and clinicians have been trying to understand why the SARS-CoV-2 virus causes such deadl
...
Written By:
Carmen Leitch
FEB 08, 2021
Technology
A blood count is essential to ascertain a patient’s health. One of the parameters measured is hemoglobin level&mda
...
Written By:
Nouran Amin
SEP 21, 2020
Immunology
Over 85 massive wildfires have swept through the West Coast, devastating communities in Washington, Oregon, and Californ
...
Written By:
Tara Fernandes
AUG 17, 2020
Immunology
A protein produced by the nervous system seems to play a role in regulating the immune system. For people with inflammat
...
Written By:
Kara Marker
JUL 23, 2020
Immunology
Scientists at the Stanford Institute for Stem Cell Biology and Regenerative Medicine have discovered a striking parallel
...
Written By:
Tara Fernandes
APR 19, 2020
Cell & Molecular Biology
The causes of chronic obstructive pulmonary disease are unclear and there is currently no treatment, but new work may he
...
Written By:
Carmen Leitch
FEB 20, 2020
Drug Discovery & Development
Antibiotics for superbug infections? A study published in the Proceedings of the National Academy of Sciences claims tha
...
Written By:
Nouran Amin
APR 12, 2019
Health & Medicine
Sarcoidosis is an inflammatory disease that involves the formation of non-caseating granulomas, a cluster of macrop
...
Written By:
Dena Aruta
MAR 04, 2019
Health & Medicine
Sarcoidosis is a rare, granulomatous disease that is found in the lungs of 90% of people diagnosed, but it can affect an
...
Written By:
Dena Aruta
JAN 07, 2019
Drug Discovery & Development
According to a study published in the journal EBioMedicine, the very first results on the treatment of a deadly age-rela
...
Written By:
Nouran Amin
AUG 05, 2018
Genetics & Genomics
This rare type of cell seems to play a major role in cystic fibrosis.
Written By:
Carmen Leitch
JUL 09, 2018
Cardiology
Utilizing computational modeling to create a more successful tissue-engineered heart valve.
Written By:
Caitlin Williams
JUN 11, 2018
Clinical & Molecular DX
Diagnosing mild-to-moderate asthma can be difficult to diagnose, especially when scientists need to rule out other respi
...
Written By:
Kara Marker
MAY 28, 2018
Cancer
Wilms tumors occur in young children and treatment for lung metastases has included radiotherapy. A Phase III Clinical
...
Written By:
Mauri Brueggeman
MAY 15, 2018
Drug Discovery & Development
Treating the common cold has never been simple and finding effective options has baffled scientists for centuries. The c
...
Written By:
Nouran Amin
MAY 22, 2017
Cell & Molecular Biology
New lung organoids open up new research possibilities for the study of human disease.
Written By:
Carmen Leitch
FEB 26, 2017
Cardiology
Pulmonary fibrosis can inhibit breathing due to scarring in the lungs. However, fibrosis is not limited to the lungs; it
...
Written By:
Kara Marker
SEP 19, 2016
Clinical & Molecular DX
In the past year, biomedical engineers have created lab-grown heart cells, retinal nerve cells, and even vocal cords tha
...